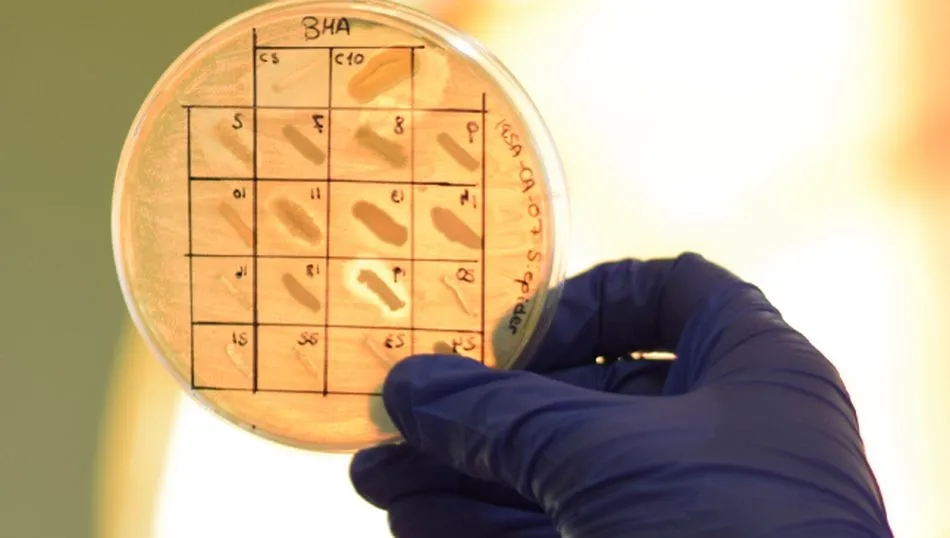

En marcha la IV edición del programa MicroMundo USAL
La iniciativa, coordinada a nivel local por el Instituto de Biología Funcional y Genómica, se centra en dar a conocer entre la ciudadanía la resistencia a los antibióticos
Once estudiantes de la Facultad de Biología de la Universidad de Salamanca forman parte del Proyecto Micromundo USAL 2021, una iniciativa de ciencia ciudadana que tiene como objetivo elaborar contenidos y actividades divulgativas para familiarizar a la población con la resistencia que desarrollan algunos microorganismos a los antibióticos, y que coordina a nivel local el Instituto de Biología Funcional y Genómica (IBFG).
Los participantes de esta iniciativa trabajan en la elaboración de contenidos y materiales de carácter divulgativo para publicar a través del blog y de las redes sociales del proyecto. Micromundo USAL se completa con la elaboración de una serie de paneles informativos para su exposición en lugares públicos, y con la organización de charlas, que se llevarán a cabo en formato en línea. En la edición de este año, sus organizadores han decidido seguir concienciando sobre la resistencia a los antibióticos, un problema de salud global que causa la muerte de miles de personas al año, y que es objeto de numerosas investigaciones científicas.
Un grupo de profesores e investigadores de la Facultad de Biología de la Universidad de Salamanca y del IBFG se encargan de tutorizar a los participantes, en una actividad que se extenderá hasta el próximo mes de mayo.
Proyecto internacional
Micromundo es una iniciativa internacional basada en un proyecto de investigación y docencia que pretende acercar la ciencia a los jóvenes de la sociedad, y concienciar a las nuevas generaciones sobre la resistencia a antibióticos. El proyecto se originó en la Universidad de Yale bajo el nombre de Small World Initiative en 2012, y la Universidad de Wiscosin lo adaptó como Tiny Earth en 2018. En nuestro país es la sociedad Española de Microbiología quien se en carga de su desarrollo.
Las actividades que se organizan en Salamanca se coordinan desde el IBFG, centro mixto de la Universidad de Salamanca y el CSIC, y cuenta con la colaboración de la Unidad de Cultura Científica y de la Innovación de la USAL, dependiente del Vicerrectorado de Investigación y Transferencia, y de la Fundación Española para la Ciencia y la Tecnología (FECYT), así como de la Facultad de Biología de la USAL y de la delegación del CSIC de Castilla y León.